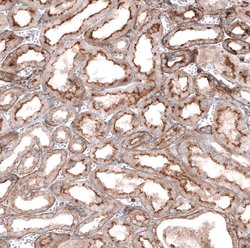
Glypican 6 Polyclonal Antibody, Invitrogen 100 &mu;L; Unconjugated:Antibodies,

missing translation for 'onlineSavingsMsg'
Learn More
Learn More
Glypican 6 Polyclonal Antibody, Invitrogen™
Rabbit Polyclonal Antibody
Brand: Invitrogen PA553622
This item is not returnable.
View return policy
Description
Immunogen sequence: KGFSLADIPY QEIAGEHLRI CPQEYTCCTT EMEDKLSQQS KLEFENLVEE TSHFVRTTFV SRHKKFDEFF RELLENAEK Highest antigen sequence identity to the following orthologs: Mouse - 100%, Rat - 100%.
The glypicans comprise a family of glycosylphosphatidylinositol-anchored heparan sulfate proteoglycans. The glypicans have been implicated in the control of cell growth and division. Glypican 6 is a putative cell surface coreceptor for growth factors, extracellular matrix proteins, proteases and anti-proteases.
Specifications
| Glypican 6 | |
| Polyclonal | |
| Unconjugated | |
| GPC6 | |
| Glypican-6 [Precursor]; Secreted glypican-6; GPC6 | |
| Rabbit | |
| Antigen affinity chromatography | |
| RUO | |
| 10082 | |
| Store at 4°C short term. For long term storage, store at -20°C, avoiding freeze/thaw cycles. | |
| Liquid |
| Immunocytochemistry, Immunofluorescence, Immunohistochemistry | |
| 0.05 mg/mL | |
| PBS with 40% glycerol and 0.02% sodium azide; pH 7.2 | |
| Q9Y625 | |
| GPC6 | |
| Recombit protein corresponding to Human Glypican 6 | |
| 100 μL | |
| Primary | |
| Human | |
| Antibody | |
| IgG |
Product Content Correction
Your input is important to us. Please complete this form to provide feedback related to the content on this product.
Product Title
Research Use Only
Spot an opportunity for improvement?Share a Content Correction